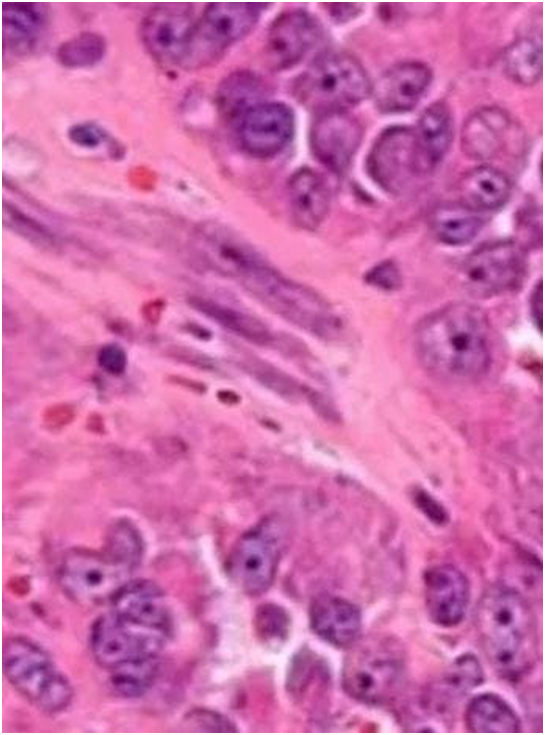

ctDNA Could Serve as a Prognostic Tool in China for Predicting Outcomes in DLBCL
September 12, 2022Lisa AstorResults from a retrospective analysis presented during the 2022 ESMO Congress indicated that circulating tumor DNA could potentially be leveraged as a prognostic factor and
Updated on: October 24,2023
ctDNA Could Serve as a Prognostic Tool in China for Predicting Outcomes in DLBCL
September 12, 2022Lisa AstorResults from a retrospective analysis presented during the 2022 ESMO Congress indicated that circulating tumor DNA could potentially be leveraged as a prognostic factor and
Updated on:October 24,2023